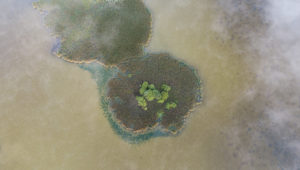

Czasami warto zmienić perspektywę i spojrzeć na świat z dystansu. Wtedy okazuje się, że istnieją inne wymiary rzeczywistości.
Zapraszam na nowy, autorski cykl obrazów przyrody Pojezierza Brodnickiego.
bagienna dolina drwęcy bagna borys szpryngwald brodnica brodnicki park krajobrazowy brzozie dolina drwęcy drwęca dzike rzeki filmy z powietrza fotografia dronowa gmina brzozie gmina zbiczno gąsiorek Jezioro Mścin jezioro sumówek kurzętnik lasy lasy brodnickie mała retencja mała retencja mścin mokradła mścin nadleśnictwo brodnica natura 2000 obserwacje ptaków ochrona mokradeł ochrona przyrody ochrona rzek odtwarzanie mokradeł ostoja brodnicka ostoja ptaków ostoje ptaków pojezierze brodnickie ptaki wodno-błotne rezerwat przyrody ruda rybitwa rzeczna sumówek sumówko tereszewo tereszowskie łąki tomki zbiczno świecie nad drwęcą